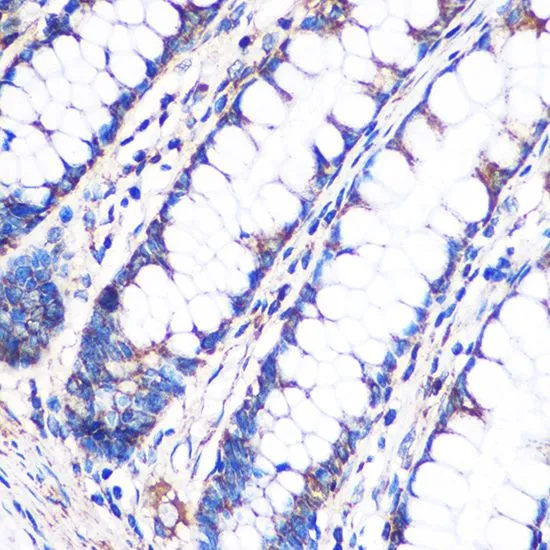

IHC-P analysis of mouse kidney tissue using GTX66244 NDUFA4L2 antibody. Dilution : 1:100
NDUFA4L2 antibody
GTX66244
ApplicationsImmunoFluorescence, Western Blot, ImmunoCytoChemistry, ImmunoHistoChemistry, ImmunoHistoChemistry Paraffin
Product group Antibodies
ReactivityHuman, Mouse, Rat
TargetCOXFA4L2
Overview
- SupplierGeneTex
- Product NameNDUFA4L2 antibody
- Delivery Days Customer9
- Application Supplier NoteWB: 1:500 - 1:2000. ICC/IF: 1:50 - 1:200. IHC-P: 1:50 - 1:200. *Optimal dilutions/concentrations should be determined by the researcher.Not tested in other applications.
- ApplicationsImmunoFluorescence, Western Blot, ImmunoCytoChemistry, ImmunoHistoChemistry, ImmunoHistoChemistry Paraffin
- CertificationResearch Use Only
- ClonalityPolyclonal
- ConjugateUnconjugated
- Gene ID56901
- Target nameCOXFA4L2
- Target descriptioncytochrome c oxidase hypoxia associated subunit FA4L2
- Target synonymsMISTRH, NDUFA4L2, NUOMS, NADH dehydrogenase [ubiquinone] 1 alpha subcomplex subunit 4-like 2, NADH dehydrogenase (ubiquinone) 1 alpha subcomplex, 4-like 2, NADH:ubiquinone oxidoreductase MLRQ subunit homolog, NDUFA4 mitochondrial complex associated like 2, cytochrome c oxidase subunit FA4 like 2, mitochondrial stress response hypoxia
- HostRabbit
- IsotypeIgG
- Protein IDQ9NRX3
- Protein NameNADH dehydrogenase [ubiquinone] 1 alpha subcomplex subunit 4-like 2
- ReactivityHuman, Mouse, Rat
- Storage Instruction-20°C or -80°C,2°C to 8°C
- UNSPSC12352203